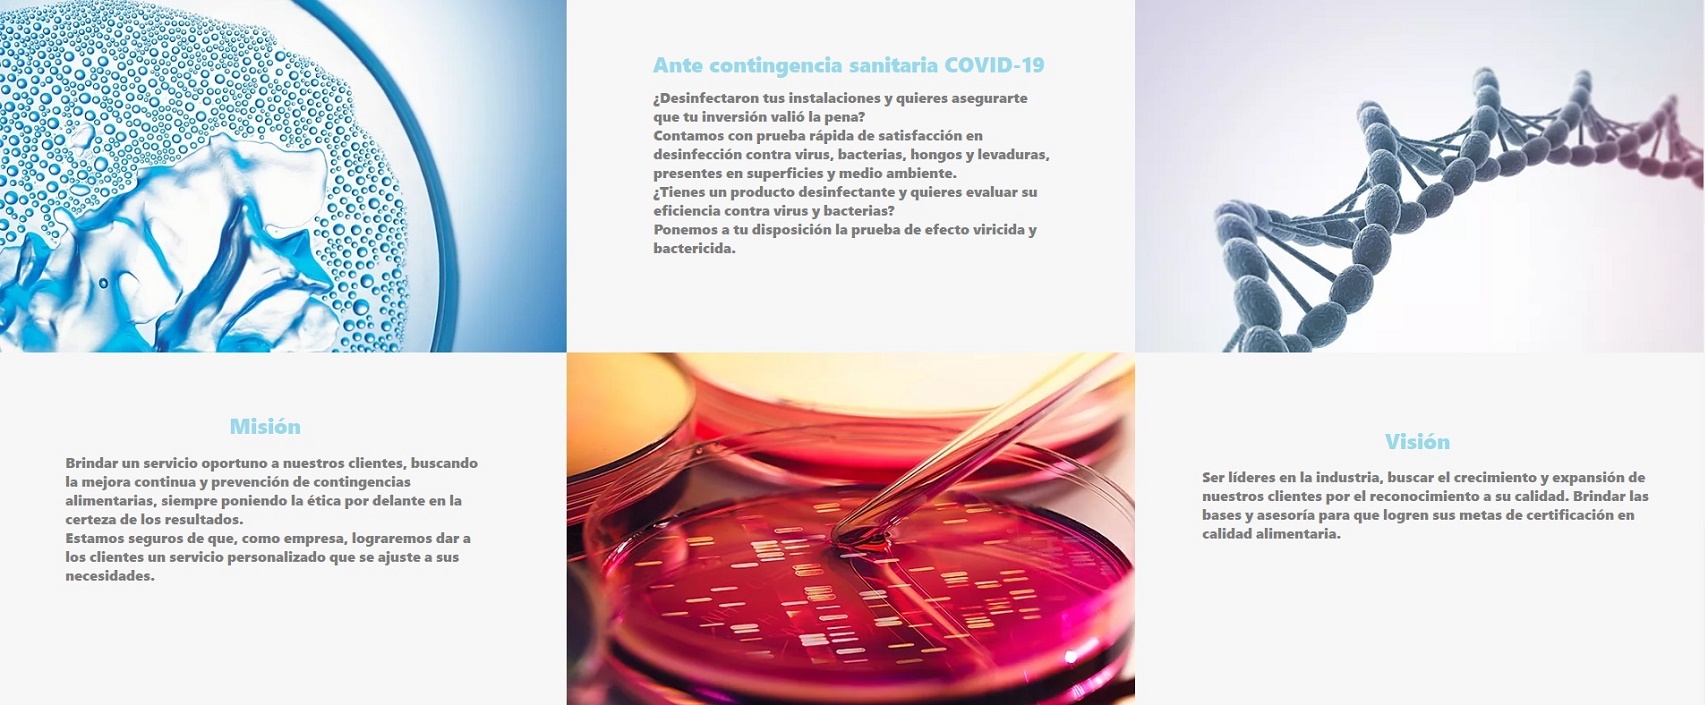

B a c t e r f i l m
B a c t e r f i l m S.A. de C.V.
Somos un equipo en constante desarrollo, en el área de calidad alimentaria con más de 10 años de experiencia.

¿Qué es lo que hacemos?
Especializados en análisis de riesgo, alimentos, agua y medio ambiente, confiable y presente las 24 horas del día.
Contáctenos
Armando Birlaing #2001 corporativo #1 piso 8 Centro sur, Querétaro, Qro. 76090
Oficina (442) 4844774 y (442) 1612241 Atención a clientes (442) 2009454
